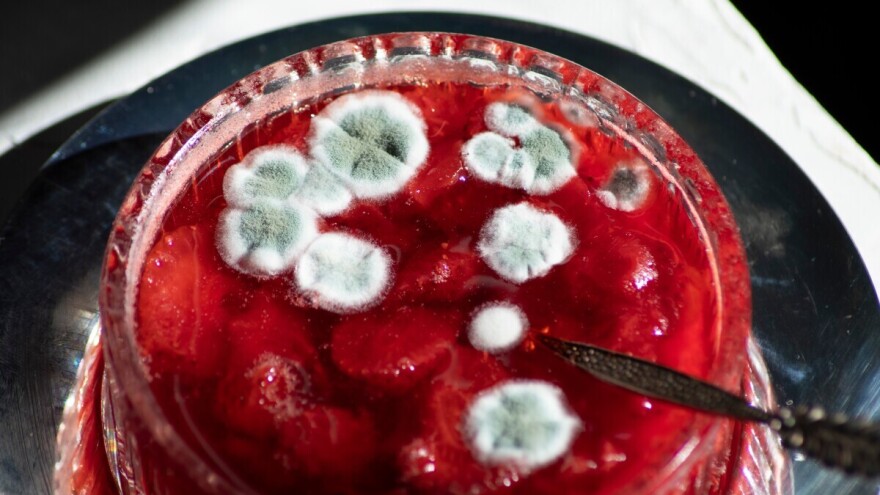
Pljesnivi džem najsigurnije je baciti, evo zašto

Plijesan se stvara kada je džem u kontaktu sa zrakom, bilo to zato što staklenka nije dobro zatvorena ili zbog toga što je bio predugo otvoren i sl.
Uklonili ste je s površine, ali niste sigurni trebate li nastaviti jesti džem ili baciti cijelu teglu.
Portal foodfacts.news je pitao stručnjake što raditi u slučaju kada je ova poslastica prekrivena plijesni.
Trebali bismo baciti svaki pljesnivi džem
S Prehrambeno - biotehnološkog fakulteta u Zagrebu dr. sc. Ksenija Markov i dr. sc. Branka Levaj kažu da uklanjanje pljesnivog dijela džema nije dovoljno da se izbjegne potencijalna opasnost po zdravlje.
“Naime, vidljiva plijesan u obliku nitastih kolonija bijele, zelene, smeđe ili crne boje samo je dio organizma koji se razvio na površini džema dok se unutar njega nalaze plijesni u obliku nevidljivih tankih niti pomoću kojih one crpe hranjive tvari“, navode.
Dodaju da je važno znati da nisu sve vrste opasne. Određene plijesni se koriste za proizvodnju antibiotika ili kao starter kulture za proizvodnju fermentiranih mliječnih i mesnih proizvoda, no neke mogu proizvoditi otrove (mikotoksine), a po izgledu i boji ne može se znati koja proizvodi, a koja ne proizvodi.
Također, mikotoksini mogu biti raspoređeni u svim slojevima džema.
Kako saznajemo, plijesni ih proizvode u svrhu odbrane od drugih mikroorganizama, ali mogu biti toksični i za ljude. “Posebno su opasni jer su toksični u vrlo malim količinama, a bez okusa su i mirisa tako da ih se pri konzumaciji hrane koja ih sadrži senzorski uopće ne osjeća“, upozoravaju ove profesorice.
Ako se progutaju njihov utjecaj može biti kratkoročan i dugoročan.
Kratkoročan utjecaj, pojašnjavaju, znači da brzo nakon konzumacije mogu izazvati gastrointestinalne probleme i povraćanje te potencijalno oštetiti organe poput bubrega i jetre dok dugoročan podrazumijeva da se mogu tokom vremena akumulirati u našem organizmu i povećati rizik od raka.
S druge strane, naglašavaju, iako džem koji je povoljan medij za rast plijesni (visok udio šećera, nizak aktivitet vode, mali raspon pH vrijednosti 3,2 – 3,4) ne sadrži vrste koje proizvode mikotoksine, plijesan porasla na površini također može značiti da ta staklenka nije bila pravilno termički tretirana ili zatvorena što isto može predstavljati opasnost po zdravlje.
“Stoga, prema mikrobiolozima trebali biste odmah baciti svaki pljesnivi džem“, poručuju zagrebačke profesorice.
Kod standardnog visokokaloričnog džema nema velike opasnosti
Profesorica s osječkog Prehrambeno - tehnološkog fakulteta, prof. dr. sc. Nela Nedić Tiban kaže da s mikrobiološke strane, džem s prisutnim plijesnima nije siguran za konzumaciju jer bez toksikološke analize ne možemo znati jesu li one koje su prisutne zaista toksikogene ili ne.
“Za stvaranje mikotoksina, plijesan mora biti genetički sposobna, ali se moraju zadovoljiti i okolišni uvjeti poput pH vrijednosti, aktiviteta vode, hranjivih tvari, temperature i drugo“, govori ona.
S druge strane, dodaje, ako je na takvim proizvodima prisutna vrsta Penicillium, što možemo pretpostaviti po bijeloj boji, možemo biti relativno sigurni i konzumirati proizvod. “No, to nije pravilo ni u kom slučaju glede vrste plijesni jer potrošači nisu u mogućnosti prepoznati različite vrste“, ističe ova profesorica.
Prema njenim riječima, u svakom slučaju, ovisno o starosnoj grupi, konzumacija takvog proizvoda nakon uklanjanja površine i sloja neposredno ispod površine ne mora biti razlogom za strah kada je u pitanju standardni, visokokalorični džem, a proizvod nakon otvaranja svakako treba čuvati u frižideru.
“S obzirom na suhu tvar koje takvi proizvodi po važećem Pravilniku o voćnim džemovima, želeima, marmeladama, pekmezu te zaslađenom kesten pireu, moraju sadržavati, a to je najmanje 60 posto, malo je vjerovatno da je moguća mikrobiološka aktivnost osim na površini proizvoda“, zaključuje univerzitetska profesorica.
U istu kategoriju spadaju i pekmez i marmelada što znači da isto vrijedi i za njih.
Važno je napomenuti također da se džemovi i ostali voćni pripravci kod kojih je skinut gornji pljesnivi sloj ne preporučuju davati djeci, a ni osobe narušenog zdravstvenog stanja ih ne bi trebale uzimati.